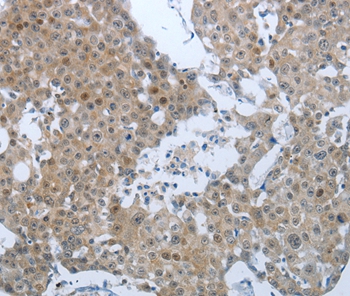

CCL15 / MIP5 Antibody (aa71-100)
LS-C168449
ApplicationsWestern Blot, ImmunoHistoChemistry, ImmunoHistoChemistry Paraffin
Product group Antibodies
TargetCCL15
Overview
- SupplierLifeSpan BioSciences
- Product NameCCL15 / MIP5 Antibody (aa71-100)
- Delivery Days Customer23
- ApplicationsWestern Blot, ImmunoHistoChemistry, ImmunoHistoChemistry Paraffin
- Applications SupplierIHC, IHC-P (1:10 - 1:50), WB (1:1000)
- CertificationResearch Use Only
- ClonalityPolyclonal
- ConjugateUnconjugated
- Estimated Purity...
- Gene ID6359
- Target nameCCL15
- Target descriptionC-C motif chemokine ligand 15
- Target synonymsC-C motif chemokine 15; chemokine (C-C motif) ligand 15; chemokine CC-2; HCC-2; HMRP-2B; leukotactin 1; LKN1; LKN-1; macrophage inflammatory protein 5; MIP-1 delta; MIP-1D; MIP-5; MRP-2B; NCC3; NCC-3; new CC chemokine 3; SCYA15; SCYL3; small inducible cytokine subfamily A (Cys-Cys), member 15; small-inducible cytokine A15; SY15
- HostRabbit
- Storage Instruction-20°C,2°C to 8°C
- UNSPSC12352203